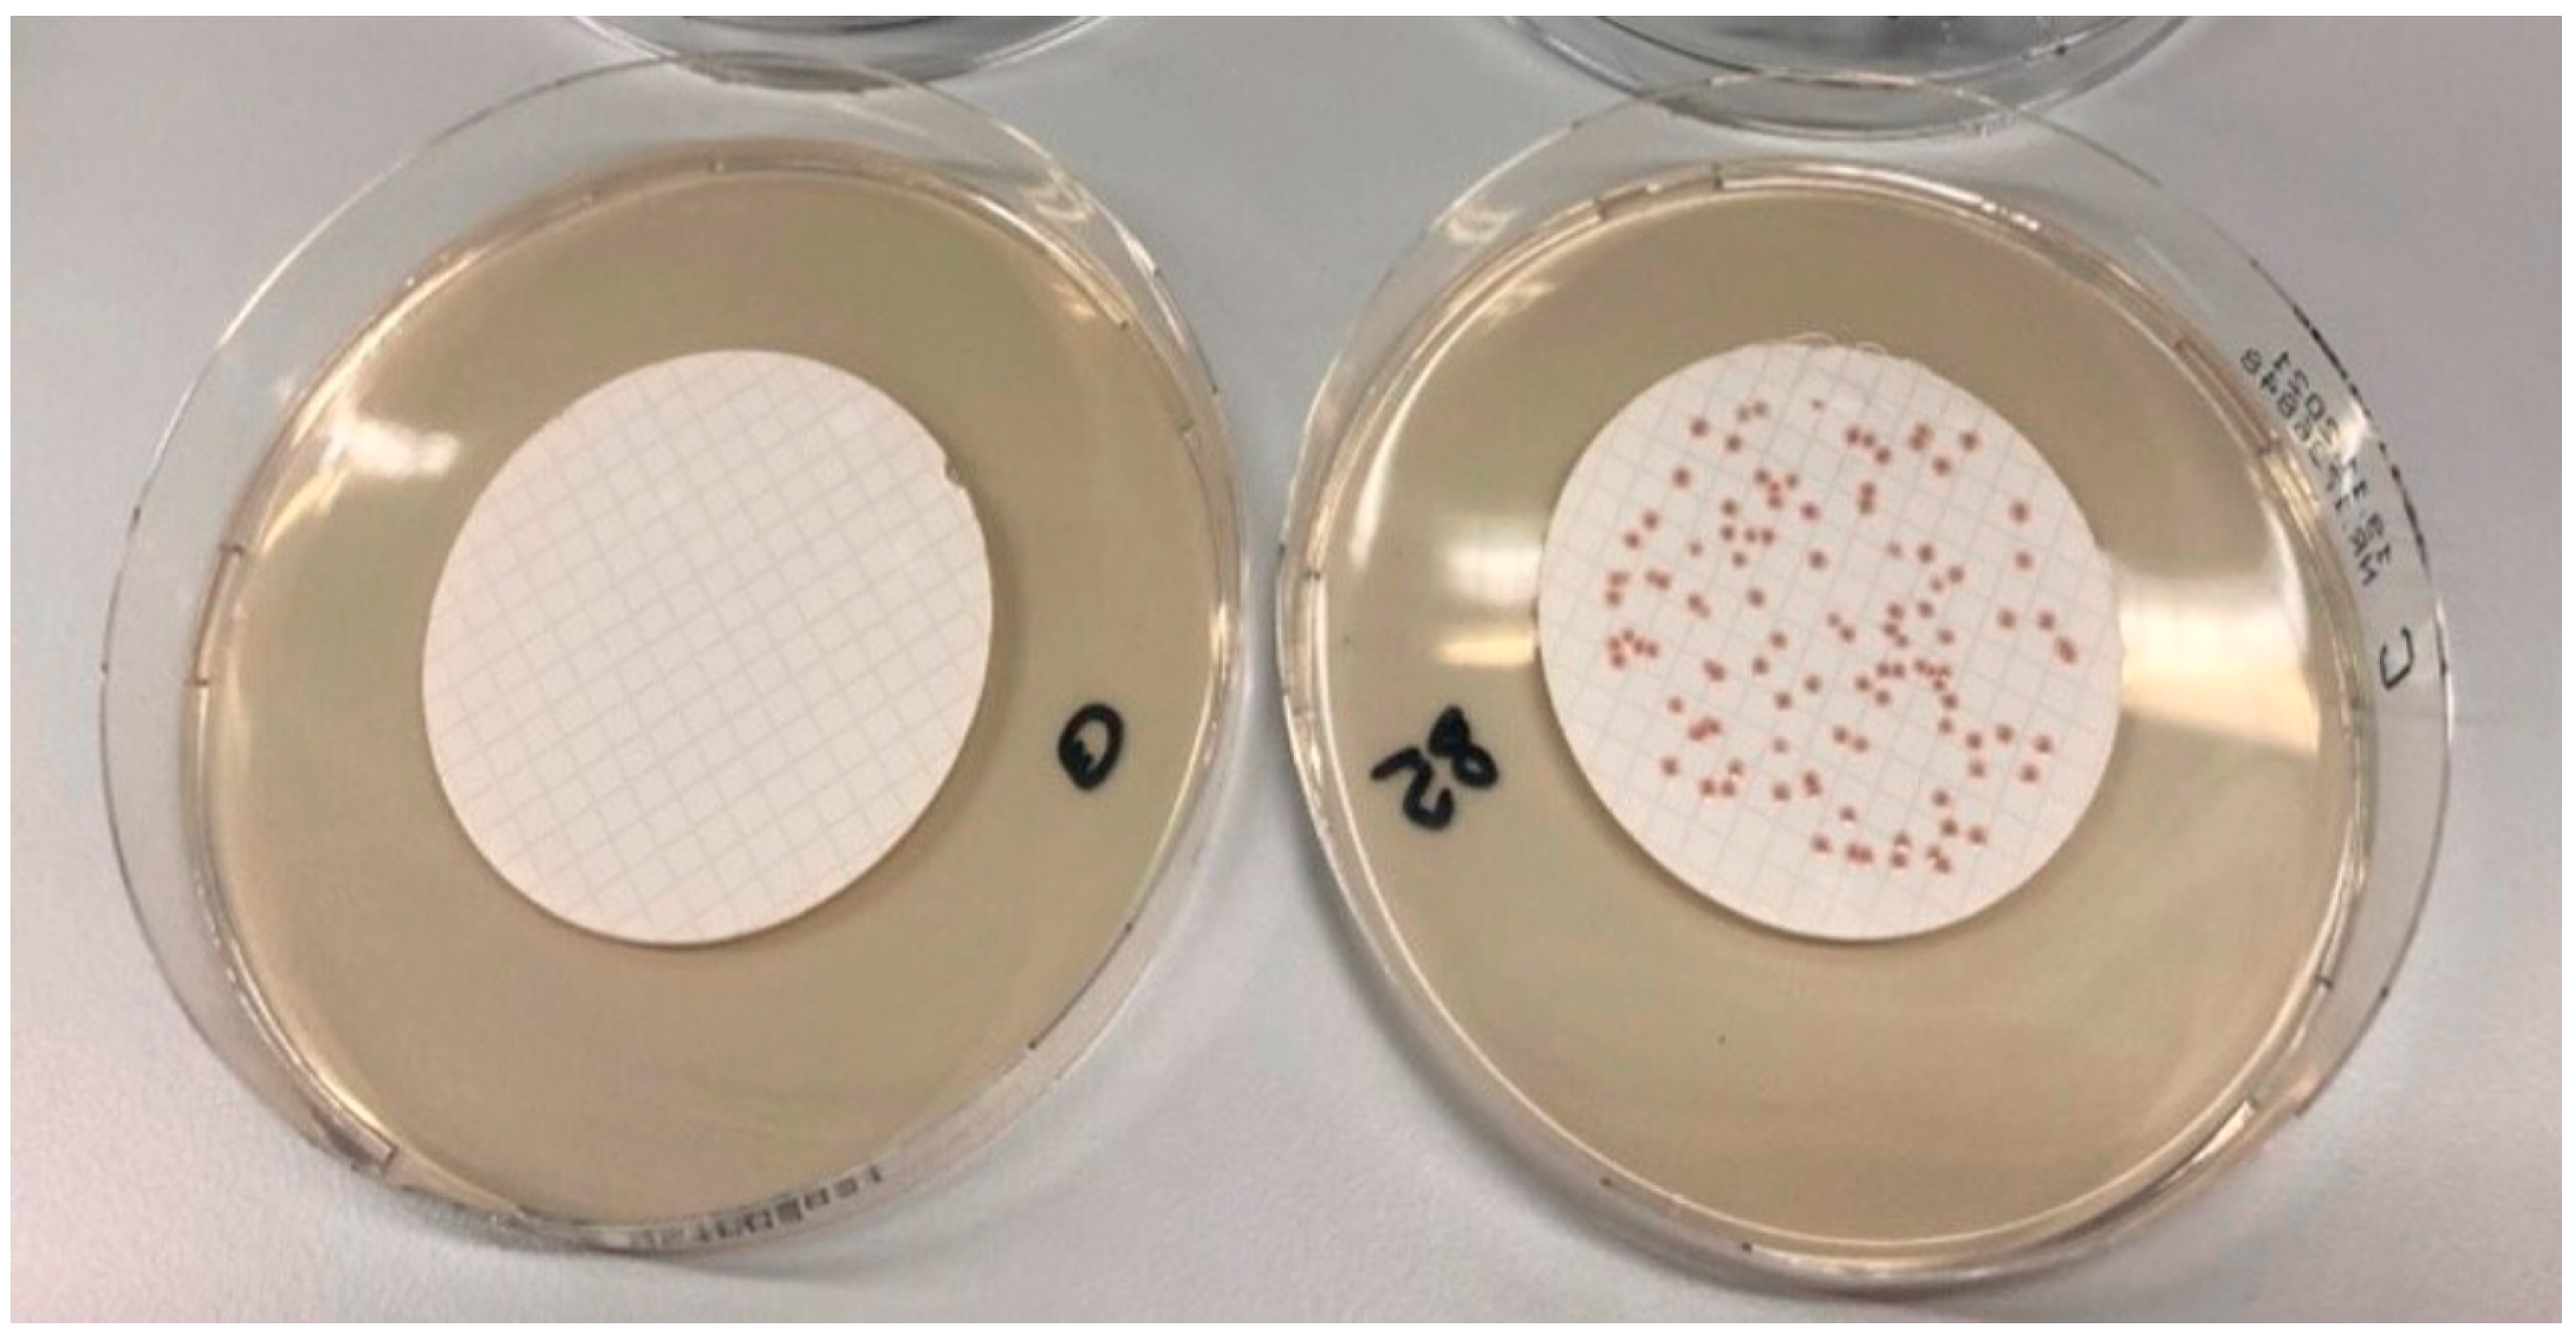
Microorganisms 10 02499 g003 Microorganisms 10 02499 g003

Cefsulodin and Vancomycin: A Supplement for Chromogenic Coliform Agar for Detection of Escherichia coli and Coliform Bacteria from Different Water Sources
Abstract
1. Introduction
2. Materials and Methods
2.1. General Methods for Sample Preparation
2.2. Relative Trueness
2.3. Preparation of E. coli and K. aerogenes Contaminated Samples
2.4. Inclusion/Exclusion Study
2.5. Sensitivity and Specificity
2.6. Preparation of CCA without Supplement
2.7. Preparation of CCA with CV Supplement
2.8. Bacterial Strains
2.9. Culture Media
2.10. Oxidase Test
2.11. Gram Staining
2.12. Data Analysis
2.13. MALDI-TOF VITEK® MS
2.14. Water Samples
3. Results and Discussion
3.1. Identification of Target Bacteria
3.2. Selectivity Studies
3.3. Relative Trueness
3.4. Accuracy Profile Study
3.5. In-House Precision and Inclusion/Exclusion Study
4. Conclusions
Supplementary Materials
Author Contributions
Funding
Data Availability Statement
Acknowledgments
Conflicts of Interest
References
- Prüss, A.; Kay, D.; Fewtrell, L.; Bartram, J. Estimating the Burden of Disease from Water, Sanitation, and Hygiene at a Global Level. Environ. Health Perspect 2002, 110, 537–542. [Google Scholar] [CrossRef]
- Moreira, N.A.; Bondelind, M. Safe drinking water and waterborne outbreaks. J. Water Health 2017, 15, 83–96. [Google Scholar] [CrossRef]
- Khan, J.R.; Hossain, M.B.; Chakraborty, P.A.; Mistry, S.K. Household drinking water E. coli contamination and its associated risk with childhood diarrhea in Bangladesh. Environ. Sci. Pollut. Res. 2022, 29, 32180–32189. [Google Scholar] [CrossRef]
- Rubino, F.; Corona, Y.; Guadalupe Jiménez Pérez, J.; Smith, C. Bacterial Contamination of Drinking Water in Guadalajara, Mexico. Int. J. Environ. Res. Public Health 2019, 16, 67. [Google Scholar] [CrossRef]
- Khan, J.R.; Bakar, K.S. Spatial risk distribution and determinants of E. coli contamination in household drinking water: A case study of Bangladesh. Int. J. Environ. Health Res. 2019, 30, 268–283. [Google Scholar] [CrossRef]
- White, K.; Dickson-Anderson, S.; Majury, A.; McDermott, K.; Hynds, P.; Brown, R.S.; Schuster-Wallace, C. Exploration of E. coli contamination drivers in private drinking water wells: An application of machine learning to a large, multivariable, geo-spatio-temporal dataset. Water Res. 2021, 197, 117089. [Google Scholar] [CrossRef]
- Bain, R.; Cronk, R.; Hossain, R.; Bonjour, S.; Onda, K.; Wright, J.; Yang, H.; Slaymaker, T.; Hunter, P.; Prüss-Ustün, A.; et al. Global assessment of exposure to faecal contamination through drinking water based on a systematic review. Trop. Med. Int. Health 2014, 19, 917–927. [Google Scholar] [CrossRef]
- Bain, R.; Cronk, R.; Wright, J.; Yang, H.; Slaymaker, T.; Bartram, J. Fecal contamination of drinking-water in low- and middle-income countries: A systematic review and meta-analysis. PLoS Med. 2014, 11, e1001644. [Google Scholar] [CrossRef]
- Geissler, K.; Manafi, M.; Amorós, I.; Alonso, J.L. Quantitative determination of total coliforms and Escherichia coli in marine waters with chromogenic and fluorogenic media. J Appl Microbiol. 2000, 88, 280–285. [Google Scholar] [CrossRef]
- Byamukama, D.; Kansiime, F.; Mach, R.L.; Farnleitner, A.H. Determination of Escherichia coli Contamination with Chromocult Coliform Agar Showed a High Level of Discrimination Efficiency for Differing Fecal Pollution Levels in Tropical Waters of Kampala, Uganda. Appl. Environ. Microbiol. 2000, 66, 864–868. [Google Scholar] [CrossRef]
- Paruch, A.M.; Maehlum, T. Specific features of Escherichia coli that distinguish it from coliform and thermotolerant coliform bacteria and define it as the most accurate indicator of faecal contamination in the environment. Ecol. Indic. 2012, 23, 140–142. [Google Scholar] [CrossRef]
- Rompré, A.; Servais, P.; Baudart, J.; de-Roubin, M.R.; Laurent, P. Detection and enumeration of coliforms in drinking water: Current methods and emerging approaches. J. Microbiol. Methods 2002, 49, 31–54. [Google Scholar] [CrossRef] [PubMed]
- Nurliyana, M.R.; Sahdan, M.Z.; Wibowo, K.M.; Muslihati, A.; Saim, H.; Ahmad, S.A.; Sari, Y.; Mansor, Z. The Detection Method of Escherichia coli in Water Resources: A Review. J. Phys. Conf. Ser. 2018, 995, 012065. [Google Scholar] [CrossRef]
- Satoh, H.; Katayose, Y.; Hirano, R. Simple enumeration of Escherichia coli concentrations in river water samples by measuring β-D-glucuronidase activities in a microplate reader. Water Sci. Technol. 2021, 83, 1399–1406. [Google Scholar] [CrossRef]
- Khan, F.M.; Gupta, R.; Sekhri, S. A convolutional neural network approach for detection of E. coli bacteria in water. Environ. Sci. Pollut. Res. 2021, 28, 60778–60786. [Google Scholar] [CrossRef] [PubMed]
- Lange, B.; Strathmann, M.; Oßmer, R. Performance validation of chromogenic coliform agar for the enumeration of Escherichia coli and coliform bacteria. Lett. Appl. Microbiol. 2013, 57, 547–553. [Google Scholar] [CrossRef] [PubMed]
- Kittinger, C.; Kirschner, A.; Lipp, M.; Baumert, R.; Mascher, F.; Farnleitner, A.H.; Zarfel, G.E. Antibiotic Resistance of Acinetobacter spp. Isolates from the River Danube: Susceptibility Stays High. Int. J. Environ. Res. Public Health 2018, 15, 52. [Google Scholar] [CrossRef]
- Larson, A.; Hartinger, S.M.; Riveros, M.; Salmon-Mulanovich, G.; Hattendorf, J.; Verastegui, H.; Huaylinos, M.L.; Mäusezahl, D. Antibiotic-Resistant Escherichia coli in Drinking Water Samples from Rural Andean Households in Cajamarca, Peru. Am. J. Trop. Med. Hyg. 2019, 100, 1363–1368. [Google Scholar] [CrossRef]
- Galler, H.; Luxner, J.; Petternel, C.; Reinthaler, F.F.; Habib, J.; Haas, D.; Kittinger, C.; Pless, P.; Feierl, G.; Zarfel, G. Multiresistant Bacteria Isolated from Intestinal Faeces of Farm Animals in Austria. Antibiot. 2021, 10, 466. [Google Scholar] [CrossRef]
- Mugadza, D.T.; Nduku, S.I.; Gweme, E.; Manhokwe, S.; Marume, P.; Mugari, A.; Magogo, C.; Jombo, T.Z. Drinking water quality and antibiotic resistance of E. coli and Salmonella spp. From different sources in Gweru urban, Zimbabwe. Environ. Monit. Assess 2021, 193, 546. [Google Scholar] [CrossRef]
- Poirel, L.; Madec, J.; Lupo, A.; Schink, A.; Kieffer, N.; Nordmann, P.; Schwarz, S. Antimicrobial Resistance in Escherichia coli. Microbiol. Spectr. 2018, 6. [Google Scholar] [CrossRef] [PubMed]
- Umstätter, F.; Domhan, C.; Hertlein, T.; Ohlsen, K.; Mühlberg, E.; Kleist, C.; Zimmermann, S.; Beijer, B.; Klika, K.D.; Haberkorn, U.; et al. Vancomycin Resistance is Overcome by Conjugation of Polycationic Peptides. Angew. Chem. Int. Ed. 2020, 59, 8823–8827. [Google Scholar] [CrossRef] [PubMed]
- Hepburn, N.F.; MacRae, M.; Johnston, M.; Mooney, J.; Ogden, I.D. Optimizing enrichment conditions for the isolation of Escherichia coli O157 in soils by immunomagnetic separation. Lett. Appl. Microbiol. 2002, 34, 365–369. [Google Scholar] [CrossRef]
- Gill, A.; Martinez-Perez, A.; McIlwham, S.; Blais, B. Development of a Method for the Detection of Verotoxin-Producing Escherichia coli in Food. J. Food Prot. 2012, 75, 827–837. [Google Scholar] [CrossRef] [PubMed]
- ÖNORM EN ISO 9308-1; Wasserbeschaffenheit—Zählung von Escherichia coli und coliformen Bakterien—Teil 1: Membranfiltrationsverfahren für Wässer mit niedriger Begleitflora. Austrian Standards Institute: Vienna, Austria, 2017.
- ÖNORM EN ISO 16140-4; Mikrobiologie der Lebensmittelkette—Verfahrensvalidierung Teil 4: Arbeitsvorschrift für Einzel-Labor-Verfahrensvalidierung. Austrian Standards International: Vienna, Austria, 2021.
- Parker, J.L.; Shaw, J.G. Aeromonas spp. clinical microbiology and disease. J Infect. 2011, 62, 109–118. [Google Scholar] [CrossRef] [PubMed]
- Ritter, T.K.; Wong, C. Carbohydrate-Based Antibiotics: A New Approach to Tackling the Problem of Resistance. Angew. Chem. Int. Ed. 2001, 40, 3508–3533. [Google Scholar] [CrossRef]
- Schalli, M.; Weber, P.; Tysoe, C.; Pabst, B.; Thonhofer, M.; Paschke, E.; Stütz, A.E.; Tschernutter, M.; Windischhofer, W.; Withers, S.G. A new type of pharmacological chaperone for GM1-gangliosidosis related human lysosomal β-galactosidase: N-Substituted 5-amino-1-hydroxymethyl-cyclopentanetriols. Bioorg. Med. Chem. Lett. 2017, 27, 3431–3435. [Google Scholar] [CrossRef]
- Schalli, M.; Wolfsgruber, A.; Gonzalez-Santana, A.; Tysoe, C.; Fischer, R.; Stütz, A.E.; Thonhofer, M.; Withers, S.G. C-5a-substituted validamine type glycosidase inhibitors. Carbohydr. Res. 2017, 440–441, 1–9. [Google Scholar] [CrossRef]
- Hubbard, B.K.; Walsh, C.T. Der Aufbau von Vancomycin: So macht es die Natur. Angew. Chem. 2003, 115, 752–789. [Google Scholar] [CrossRef]
- Alonso, J.L.; Amoros, I.; Alonso, M.A. Differential Susceptibility of Aeromonads and Coliforms to Cefsulodin. Appl. Environ. Microbiol. 1996, 62, 1885–1888. [Google Scholar] [CrossRef]
- Neu, H.C.; Scully, E. Activity of Cefsulodin and Other Agents Against Pseudomonas aeruginosa. Rev. Infect. Dis. 1984, 6, 667–677. [Google Scholar] [CrossRef] [PubMed]
- ISO 8199; Water quality—General requirements and guidance for microbiological examinations by culture. International Standards Organisation: Geneva, Swiss, 2018.
- Feltham, R.K.A.; Power, A.K.; Pell, P.A.; Sneath, P.H.A. A simple method for storage of bacteria at −76 °C. J. appl. Bacterial. 1978, 44, 313–316. [Google Scholar] [CrossRef] [PubMed]
- ÖNORM EN ISO 10523; Wasserbeschaffenheit–Bestimmung des pH-Wertes. Austrian Standards Institute: Vienna, Austria, 2012.
- ÖNORM EN 27888; Wasserbeschaffenheit–Bestimmung der elektrischen Leitfähigkeit. Österreichisches Normungsinstitut: Vienna, Austria, 1993.
- ÖNORM EN ISO 16140-2; Mikrobiologie der Lebensmittelkette–Verfahrensvalidierung Teil 2: Arbeitsvorschrift für die Validierung von alternativen (urheberrechtlich geschützten) Verfahren anhand eines Referenzverfahrens. Austrian Standards Institute: Vienna, Austria, 2016.
- DIN EN ISO 13843; Water quality—Requirements for establishing performance characteristics of quantitative microbiological methods. Austrian Standards International: Vienna, Austria, 2018.

| Setting | Item | Factor 1: | Factor 2: | Factor 3: | Factor 4: |
|---|---|---|---|---|---|
| Technician | Culture Media (Charge) | Incubation Temperature (°C) | Incubation Time (h) | ||
| 1 | 1,2,3 | 1 | a | 34.5 | 21 |
| 2 | 1,2,3 | 2 | b | 37.0 | 24 |
| 3 | 4,5,6 | 1 | b | 34.5 | 24 |
| 4 | 4,5,6 | 2 | a | 37.0 | 21 |
| 5 | 7,8,9 | 1 | b | 37.0 | 21 |
| 6 | 7,8,9 | 2 | a | 34.5 | 24 |
| 7 | 10,11,12 | 1 | a | 37.0 | 24 |
| 8 | 10,11,12 | 2 | b | 34.5 | 21 |
| Category | Type | pH-Value | Electrical Conductivity (µS/m) | Colony Forming Units (CFU/mL) |
|---|---|---|---|---|
| A | 7.58 | 656 | <1 | |
| α | B | 6.84 | 382 | <1 |
| C | 6.98 | 227 | >300 | |
| D | 7.72 | 443 | <1 | |
| E | 7.27 | 834 | <1 | |
| β | F | 7.29 | 735 | <1 |
| G | 7.19 | 1088 | <1 | |
| H | 8.04 | 4979 | >300 | |
| I | 6.96 | 479 | 226 | |
| γ | J | 5.31 | 503 | <1 |
| K | 5.25 | 495 | <1 | |
| L | 6.33 | 4624 | <1 |
| Reference Method | Alternative Method | ||
|---|---|---|---|
| Identification | n = 338 | n = 251 | |
| Sensitivity [%] | 85.3 | 82.2 | |
| Specificity [%] | 97.3 | 98.6 | |
| False positive rate [%] | 3.8 | 0.7 | |
| False negative rate [%] | 10.7 | 31.4 | |
| Selectivity [%] | 37.9 | 59.0 | |
| Repeatability | |||
| Category | |||
| (E. coli) | α | 0.055 | 0.075 |
| β | 0.066 | 0.114 | |
| γ | 0.052 | 0.083 | |
| (K. aerogenes) | α | 0.056 | 0.051 |
| β | 0.060 | 0.065 | |
| γ | 0.057 | 0.078 | |
| Reproducibility | |||
| Category | |||
| (E. coli) | α | 0.055 | 0.075 |
| β | 0.081 | 0.114 | |
| γ | 0.054 | 0.083 | |
| (K. aerogenes) | α | 0.056 | 0.053 |
| β | 0.060 | 0.065 | |
| γ | 0.060 | 0.080 | |
| Reference Strain | [A] (CFU) | [B] (CFU) | [C] (CFU) | |||
|---|---|---|---|---|---|---|
| Enterobacter cloacae DSM 30054 | 64 | 67 | 59 | 56 | 67 | 69 |
| Escherichia coli DSM 1103 | 85 | 83 | 68 | 75 | 85 | 80 |
| Escherichia coli DSM 1576 | 86 | 82 | 88 | 85 | 85 | 79 |
| Escherichia coli DSM 5210 | 74 | 81 | 71 | 80 | 78 | 85 |
| Escherichia coli DSM 5695 | 61 | 55 | 53 | 56 | 52 | 56 |
| Escherichia coli DSM 5923 | 48 | 51 | 45 | 47 | 53 | 49 |
| Escherichia coli UTI DSM 10814 | 72 | 60 | 72 | 74 | 71 | 64 |
| Escherichia coli DSM 11250 | 76 | 83 | 79 | 82 | 80 | 84 |
| Escherichia coli DSM 18039 | 84 | 79 | 75 | 69 | 80 | 76 |
| Escherichia coli DH5 alpha | 79 | 84 | 78 | 75 | 85 | 87 |
| Escherichia coli K12 | 48 | 51 | 46 | 49 | 52 | 60 |
| Klebsiella aerogenes DSM30053 | 75 | 79 | 76 | 74 | 84 | 71 |
| Klebsiella sp. DSM 4798 | 97 | 98 | 96 | 93 | 95 | 84 |
| Klebsiella pneumoniae ATCC 4352 | 78 | 75 | 67 | 62 | 80 | 77 |
| Klebsiella pneumonae DSM 789 | 58 | 55 | 59 | 53 | 64 | 68 |
| Klebsiella pneumonae DSM 26371 | 67 | 76 | 65 | 72 | 69 | 59 |
| Klebsiella pneumonae DSM 30104 | 62 | 74 | 65 | 58 | 58 | 63 |
| Klebsiella variicola strain: ATCC 31488 | 78 | 86 | 84 | 85 | 76 | 81 |
| Reference Strain | [A] (CFU) | [B] (CFU) | ||
|---|---|---|---|---|
| Aeromonas caviae DSM 7323 | 74 | 89 | 0 | 0 |
| Aeromonas hydrophila DSM 30187 | 85 | 79 | 0 | 0 |
| Acinetobacter baumannii DSM 30007 | 93 | 86 | 52 | 61 |
| Acinetobacter calcoaceticus DSM 30006 | 53 | 60 | 0 | 0 |
| Acinetobacter Iwoffii DSM 2403 | 77 | 65 | 0 | 0 |
| Proteus mirabilis DSM 788 | 70 | 77 | 65 | 63 |
| Pseudomonas aeruginosa DSM 939 | 78 | 88 | 0 | 0 |
| Pseudomonas aeruginosa DSM 1117 | 79 | 86 | 0 | 0 |
| Pseudomonas aeruginosa DSM 1128 | 82 | 89 | 0 | 0 |
| Pseudomonas aeruginosa DSM 50071 | 85 | 90 | 0 | 0 |
| Salmonella enterica subsp. enterica DSM 17420 | 80 | 75 | 78 | 69 |
| Salmonella enterica DSM 19587 | 66 | 61 | 54 | 49 |
Publisher’s Note: MDPI stays neutral with regard to jurisdictional claims in published maps and institutional affiliations. |
© 2022 by the authors. Licensee MDPI, Basel, Switzerland. This article is an open access article distributed under the terms and conditions of the Creative Commons Attribution (CC BY) license (https://creativecommons.org/licenses/by/4.0/).
Share and Cite
Schalli, M.; Inwinkl, S.M.; Platzer, S.; Baumert, R.; Reinthaler, F.F.; Ofner-Kopeinig, P.; Haas, D. Cefsulodin and Vancomycin: A Supplement for Chromogenic Coliform Agar for Detection of Escherichia coli and Coliform Bacteria from Different Water Sources. Microorganisms 2022, 10, 2499. https://doi.org/10.3390/microorganisms10122499
Schalli M, Inwinkl SM, Platzer S, Baumert R, Reinthaler FF, Ofner-Kopeinig P, Haas D. Cefsulodin and Vancomycin: A Supplement for Chromogenic Coliform Agar for Detection of Escherichia coli and Coliform Bacteria from Different Water Sources. Microorganisms. 2022; 10(12):2499. https://doi.org/10.3390/microorganisms10122499
Chicago/Turabian StyleSchalli, Michael, Sarah Maria Inwinkl, Sabine Platzer, Rita Baumert, Franz F. Reinthaler, Petra Ofner-Kopeinig, and Doris Haas. 2022. "Cefsulodin and Vancomycin: A Supplement for Chromogenic Coliform Agar for Detection of Escherichia coli and Coliform Bacteria from Different Water Sources" Microorganisms 10, no. 12: 2499. https://doi.org/10.3390/microorganisms10122499
APA StyleSchalli, M., Inwinkl, S. M., Platzer, S., Baumert, R., Reinthaler, F. F., Ofner-Kopeinig, P., & Haas, D. (2022). Cefsulodin and Vancomycin: A Supplement for Chromogenic Coliform Agar for Detection of Escherichia coli and Coliform Bacteria from Different Water Sources. Microorganisms, 10(12), 2499. https://doi.org/10.3390/microorganisms10122499

